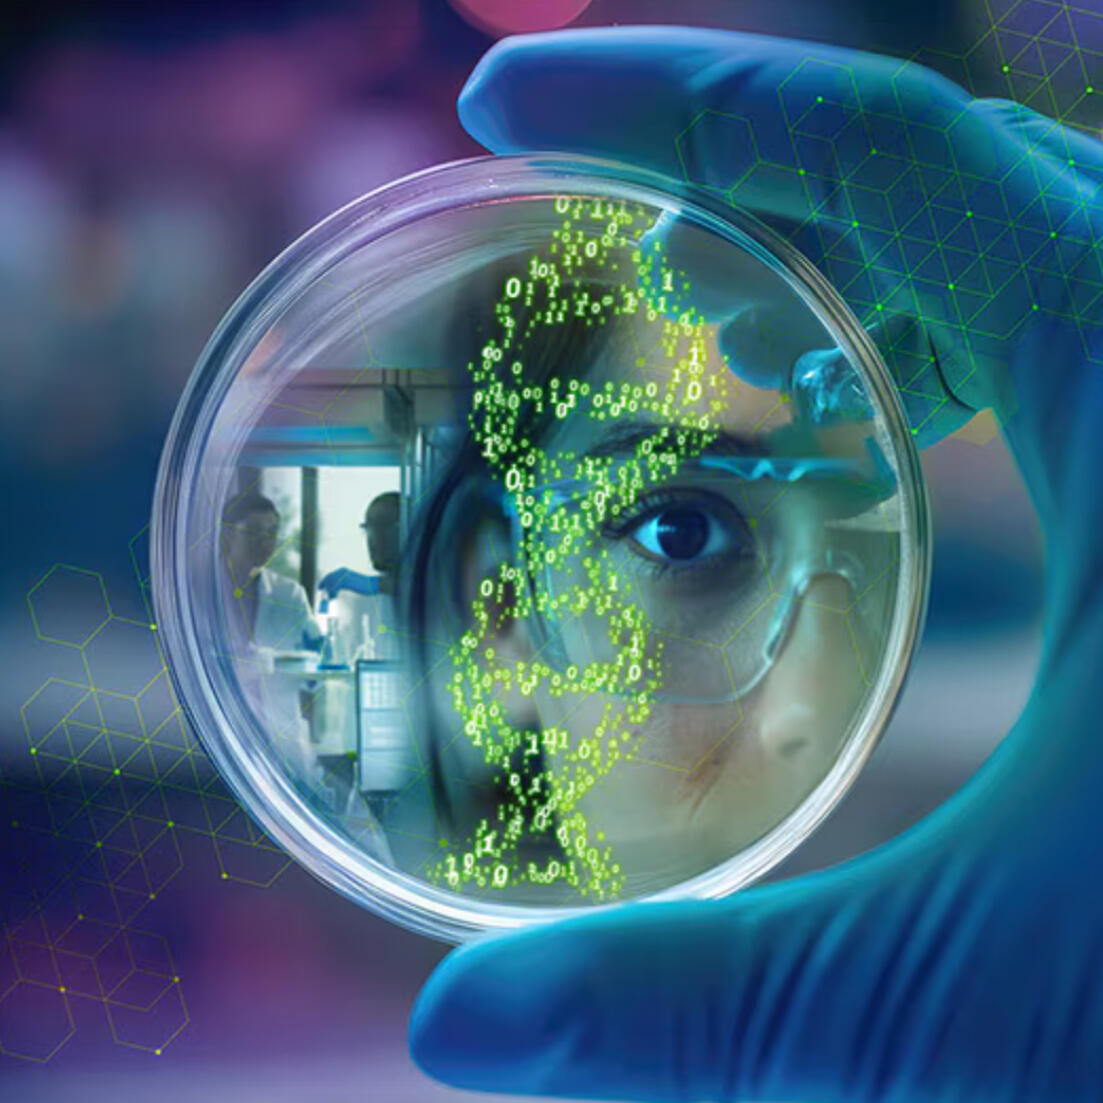
xTech Futures: BioTech

📍NYC & LA
Master of bits and bytes. Research leader, software engineer, public speaker, and executive report author. Helping organizations arrive at the future just a little ahead of schedule.
LinkedIn Top Voice in AI
Keynote Speaker
GenAI, Agents, & LLMs
Emerging Technology Research
For consulting or speaking requests, please click the email icon above.
A quick bio...
I'm the Founder of AIExperts.com — a one-stop shop for automating small and mid-sized businesses. With my background in computer science and a decade of hands-on experience in tech, I've helped everyone from scrappy startups to Fortune 500 executives harness the power of AI, automation, and intelligent agents.
After spending five years working directly with Deloitte's CTO Bill Briggs and Chief Futurist Mike Bechtel, advising some of the world's largest companies on staying ahead of the curve, I now bring that same insight to business owners who want to move fast and think big.
I believe the speed of imagination is now the speed of creation — and there's never been a better time to turn automation into a competitive edge. Whether you're running a dealership or scaling a digital-first business, I can break down how AI agents, tools like ChatGPT and Microsoft Copilot, and smart automation can free up time, boost margins, and create space for the kind of work humans do best.
My background
I got my start in tech early as a curious high school robotics engineer. That curiosity landed me a rare spot as one of the youngest interns at HP's network test lab, where I contributed to a multi-million-dollar deal and presented innovations directly to senior executives. In college, I channeled that drive into AI, building award-winning applications for image classification and predictive analytics at UC Irvine's Donald Bren School of Information and Computer Science. After that, I knew I wanted to help decision-makers see the big picture of technology.
At Deloitte, I worked on the Novel and Exponential Technologies (NExT) team led by Chief Futurist Mike Bechtel, researching emerging technologies and helping Fortune 500 clients prepare for future disruptions. Working closely with CTO Bill Briggs, I gained invaluable insights into how technology shapes business strategy at the highest levels. I've given presentations on everything from the future of AI to the transformative potential of data-informed biotech, always with an eye toward practical applications and real-world impact.
I'm also passionate about making AI accessible and understandable.
From uploading my personal journals to AI for self-reflection to building sentiment analysis tools for social media, I enjoy experimenting with AI in creative ways that demonstrate its potential beyond the buzzwords.
Today, I see AI not just as a business tool — but as a great equalizer. I believe it can help anyone, regardless of background, catapult their career or company forward. Having entered the tech world without connections, I'm passionate about creating opportunities for the next generation of builders and thinkers. Because when experimentation is accessible, innovation follows — and anyone with the curiosity to learn deserves a shot.

AI Experts

CES Show Floor Walk and Talk with the CTO of Deloitte

AI walk and talk with Bill Briggs, CTO of Deloitte

Tech Trends 2025
xTech Futures: BioTech

Tech Trends 2024

I gave AI access to 5 years of my personal journals

AI and the changing climate

Is AI the solution to search's problem?

xTech Futures: SpaceTech

sharpened.co

Tech Trends

Technology Futures 2021

Three Lessons from Puerto Rico Blockchain Week

Apple Vision Pro: Spatial Computing
Lucas has been a keynote speaker on Global stages from Switzerland to Puerto Rico to New York City.
Speaker intro:
Lucas is the Founder of AIExperts.com — a one-stop shop for automating small and mid-sized businesses. He is a published author, keynote speaker, and a member of LinkedIn's distinguished, invite-only "Top Voice" program. With a background in computer science and big data, he’s spent the last decade in tech as both a software engineer and consultant. For the past five years, he’s advised Fortune 500 executives on emerging technologies like AI and automation. Today, he helps business leaders make confident, strategic bets in an increasingly fast-moving landscape.If you would like a presentation on one of these topics please email: lucas@lucaserb.com
For consulting or speaking requests, please click the email icon below.
A rolling feed of my musings on the internet
By: Lucas ErbHow to tell we're in an AI bubble: 😂Real talk, I see a lot of misuse of the terms AI, GenAI, Machine Learning, Deep Learning and the like.I would be VERY surprised if this toothbrush passes as "AI" even by the broadest definition of any of the words listed above.AI, in classical computer science would require trained models and likely more computation than exists in a toothbrush to make classifications and predictions."Better code" != "AI"I understand the social pressure to jump on the AI trend in business and marketing. This may very well be the smartest toothbrush ever made, and how can you succinctly explain that to consumers?But still... give me a break.What's the most shocking example you've seen of AI overuse?Source: https://www.linkedin.com/feed/update/urn:li:activity:7178056015777562625------------------------------------I shared a beer with the CTO of Deloitte Consulting in NYC! Here's what I learned.Bill Briggs is my leader at Deloitte, and a leader to many.In his garage he hand crafted multiple full-sized pinball machines from scratch.And machined and programmed a life-sized, custom coded, R2-D2 robot!Far from the typical corporate suit and tie affair, Bill is a real techy.I've often heard the criticism of consultants that we're lacking in hard-skills."Soft-skills wizards, but tech-skills muggles pitching ideas for solutions we can hardly deliver."Bill, leading Deloitte Consulting's deep-tech teams, is proof that's not the case.Far from just being toys, these projects are proof of a person who will never stop learning.This requires proficient to advanced skills in a whole suite of gadgets:
- Electrical Engineering
- CAD design
- Arduino Programming
- Servo Motor Calibration
- Woodworking
- CNC MachiningIf you've ever seen Adam Savage of Myth Busters fame build a cool toy on his YouTube channel, Tested, you know exactly what I mean.It takes an artisan, an engineer, and a polymath to apply all these skills.And Bill does all this while leading strategy for Fortune 500 clients.Cheers to the geeks, the nerds, and the pioneers.You have a home here. Let's keep building.#programming#engineering#deloitteconsultingSource: https://www.linkedin.com/feed/update/urn:li:activity:7224048735310278657------------------------------------On my flight today from NYC I noticed a piece missing from the wing of my plane!Initially I thought about telling the flight attendant, but decided against in case repair would delay my flight. 🫢Gross negligence on my part?Maybe. But I have a Deloitte meeting to catch in Salt Lake.Just to be safe, I started feverishly googling what this piece of the wing is for and found similar concerns from other passengers.They’re called “flap track fairings”.These flap covers are entirely unnecessary for the safety of an aircraft. Whew.However they are responsible for a π % decrease in fuel consumption on the flight! Source: an Airbus flight manual I found on Google.A 3.14% decrease in fuel from a CONE?This reminds me of a similar story I heard from Daniel Lockney head of NASA’s Tech Transfer Program.In the 70s NASA - National Aeronautics and Space Administration discovered that aircraft “winglets” (little curved tips to the wing) could amount to a 6.5% reduction in fuel consumption for commercial flight.Now they’re on nearly every plane.So the big question is… What slight change to “business as usual” are we missing today which could pay handsomely in efficiency or sustainability tomorrow?#engineering#stem#futures#technology#deloitteconsulting#sustainability#strategySource: https://www.linkedin.com/feed/update/urn:li:activity:7136001044991397888------------------------------------𝐀𝐈 𝐰𝐚𝐥𝐤 𝐚𝐧𝐝 𝐭𝐚𝐥𝐤 🤖Bill Briggs, CTO of Deloitte gives us an inside-look into board room conversations about AI and how to think about innovation.Bill started his career as an Engineer and has over 25 years of experience leading the charge on emerging technology priorities for Deloitte!He’s also one of the leaders backing this 𝐀𝐩𝐩𝐥𝐢𝐞𝐝 𝐀𝐈 𝐍𝐞𝐰 𝐇𝐨𝐫𝐢𝐳𝐨𝐧𝐬 𝐒𝐮𝐦𝐦𝐢𝐭: a deep-dive into data science, ML, and GenAI for over 250 AI Experts at Deloitte.“𝑌𝑜𝑢 𝑑𝑜𝑛’𝑡 ℎ𝑎𝑣𝑒 𝑡𝑜 𝑝𝑢𝑡 𝑜𝑛 𝑐𝑢𝑓𝑓-𝑙𝑖𝑛𝑘𝑠 𝑡𝑜 𝑏𝑒 𝑎 𝑝𝑎𝑟𝑡𝑛𝑒𝑟 ℎ𝑒𝑟𝑒, 𝑦𝑜𝑢 𝑐𝑎𝑛 𝑏𝑒 𝑟𝑒𝑎𝑙𝑙𝑦 𝑑𝑒𝑒𝑝 𝑖𝑛𝑡𝑜 𝑡ℎ𝑒 𝑐𝑜𝑚𝑚𝑎𝑛𝑑 𝑙𝑖𝑛𝑒. 𝐷𝑜𝑛’𝑡 𝑡𝑒𝑙𝑙 𝑚𝑒 𝑤ℎ𝑎𝑡 𝑦𝑜𝑢 𝑘𝑛𝑜𝑤, 𝑠ℎ𝑜𝑤 𝑚𝑒 𝑤ℎ𝑎𝑡 𝑦𝑜𝑢 𝑑𝑜. 𝑁𝑜𝑡 𝑒𝑣𝑒𝑟𝑦𝑜𝑛𝑒 𝑛𝑒𝑒𝑑𝑠 𝑡𝑜 𝑔𝑜 𝑓𝑜𝑟 𝑡ℎ𝑒 𝑃ℎ𝐷-𝑙𝑒𝑣𝑒𝑙 𝑐𝑒𝑟𝑡𝑖𝑓𝑖𝑐𝑎𝑡𝑖𝑜𝑛 𝑎𝑛𝑑 𝑑𝑒𝑝𝑡ℎ, 𝑏𝑢𝑡 𝑒𝑣𝑒𝑟𝑦𝑜𝑛𝑒 𝑠ℎ𝑜𝑢𝑙𝑑 𝑏𝑒 ℎ𝑎𝑛𝑑𝑠 𝑜𝑛, 𝑒𝑥𝑝𝑒𝑟𝑖𝑚𝑒𝑛𝑡𝑖𝑛𝑔 𝑎𝑛𝑑 𝑙𝑒𝑎𝑟𝑛𝑖𝑛𝑔 𝑚𝑜𝑟𝑒. 𝑇ℎ𝑎𝑡 𝑖𝑠 𝑡ℎ𝑒 𝑠𝑝𝑖𝑟𝑖𝑡 𝑜𝑓 𝑡ℎ𝑖𝑠 𝑡ℎ𝑖𝑛𝑔.”“𝐷𝑒𝑙𝑜𝑖𝑡𝑡𝑒 𝑖𝑠 𝑎 𝑡𝑒𝑐ℎ𝑛𝑜𝑙𝑜𝑔𝑦 𝑐𝑜𝑚𝑝𝑎𝑛𝑦. 𝑇ℎ𝑒 𝑤𝑜𝑟𝑙𝑑 𝑚𝑖𝑔ℎ𝑡 𝑛𝑜𝑡 𝑘𝑛𝑜𝑤 𝑖𝑡 𝑦𝑒𝑡 𝑖𝑛 𝑒𝑣𝑒𝑟𝑦 𝑝𝑜𝑐𝑘𝑒𝑡, 𝑏𝑢𝑡 𝐼’𝑚 𝑝𝑟𝑜𝑢𝑑 𝑡ℎ𝑎𝑡 𝑤𝑒’𝑟𝑒 𝑡𝑒𝑙𝑙𝑖𝑛𝑔 𝑡ℎ𝑎𝑡 𝑠𝑡𝑜𝑟𝑦 𝑙𝑜𝑢𝑑𝑙𝑦 𝑎𝑛𝑑 𝑜𝑢𝑟 𝑝𝑒𝑜𝑝𝑙𝑒 𝑝𝑟𝑜𝑣𝑒 𝑖𝑡 𝑒𝑣𝑒𝑟𝑦 𝑑𝑎𝑦 𝑡ℎ𝑒𝑦 𝑠ℎ𝑜𝑤 𝑢𝑝.”Please let me know what you think!𝐖𝐡𝐚𝐭 𝐨𝐭𝐡𝐞𝐫 𝐪𝐮𝐞𝐬𝐭𝐢𝐨𝐧𝐬 𝐰𝐨𝐮𝐥𝐝 𝐲𝐨𝐮 𝐥𝐢𝐤𝐞 𝐭𝐨 𝐚𝐬𝐤 𝐁𝐢𝐥𝐥 𝐚𝐛𝐨𝐮𝐭 𝐀𝐈 𝐚𝐧𝐝 𝐢𝐧𝐧𝐨𝐯𝐚𝐭𝐢𝐨𝐧?#AI#Innovation#BoardRoomThanks to Bill Briggs for offering us a few moments of his time, Joshua Rodriguez for the bicep-fueled steady cam, to Tiffany Zamora for the interview idea.Further thank you to the executive leadership and AI Summit team for all the amazing opportunities to learn and connect.Tatiana Dominguez, Jeremy Covert, Giorgina Donati, MPH, Abria Perry, Kelly Raskovich, Shir Boger, Charmaine Charmant, MSM, Gert De Geyter, Casey Zanowicz, and Kate Schmidt. Christine Ahn, Amit Chaudhary, Jim Rowan, Eli M. Dow, Paula Payton, PhD, Rachael Nosin, Tammy Montgomery, Kenny Brown, Sanmitra Bhattacharya, PhD, Bella Shah, and Aditi GhoshSource: https://www.linkedin.com/feed/update/urn:li:activity:7256662739702398976------------------------------------I uploaded 5 years of my personal journals to AI. 📙I took photos of every single handwritten page.I wrote some AI code to extract every single line of text, one by one (Optical Character Recognition).Then I uploaded all this text to Anthropic's latest Claude 3.5 Sonnet model.📝 It has a 200k token context window and impressively fine-tuned conversation.👩⚕️ I told Claude to be a family therapist.A counselor prompted with the best methods from cognitive behavioral therapy, to psychodynamic, to humanistic.Then I asked it the real questions:
- What are my weaknesses?
- What are the goals I have set for myself over the years?
- How can I maximize my self confidence and minimize my self doubt?The answers are positively startling.I plan to make a blog about this soon so you can do the same thing.But first I need your help - what other questions should I ask the bot?#GenAI#LLM#therapy#mentalhealthSource: https://www.linkedin.com/feed/update/urn:li:activity:7221943266835927040------------------------------------The Applied AI New Horizons summit checked my ego about AI…I sort of felt like a toddler who’d wandered into a quantum physics conference. 👶Sure, I may have a CS degree, be able to toss around terms like “Stochastic Gradient Descent”, and build simple AI apps. 📊it’s all just fancy math, right? not really.this week I was reminded “software is hard and enterprise AI software is harder”:Discussions during the summit are not just how to build AI, but how to build it RIGHT:- Can we make AI which is safe: safe for our people, safe for our clients, and safe for our world?- Can we make AI which self-evaluates to keep bias, hallucinations, and private data out of prod?- Can we make AI which balances the power of prediction derived from traditional models, and the power of creation derived from generative models in tandem?It’s obviously not enough to just build a pretty demo and powerpoint slide.To realize the full value of AI we need to deploy it in the messy, real world with 1000 different variations of enterprise-grade tech stacks.At Deloitte we have PhDs who have done nothing but think about ML, Data science, and algorithms for the past 20 years.Looking at you Eli M. DowWe have leaders with deep expertise, ready to help clients realize a roadmap to data profitability and cost savings.Looking at you Jim Rowan Paula Payton, PhD Sanmitra Bhattacharya, PhD Bill Briggs Amit Chaudhary Christine AhnAnd we have a LONG tail of AI/ML talent who are actively building.They’re not all in the room this week, but in 100 other rooms across the country and the world.It is humbling to make history with you all.Here’s to our bright future!And a very special thank you to these folks who planned the whole thing. Can we make this an annual occurrence please?Tatiana Dominguez Jeremy Covert Shir Boger Giorgina Donati, MPH Abria Perry Joshua Rodriguez Charmaine Charmant, MSM Rachael N. Gert De Geyter Casey Zanowicz Kate SchmidtPS: if you’re interested in getting involved in AI work, don’t hesitate to reach out. 💪#AppliedAI#GenAI#consultingSource: https://www.linkedin.com/feed/update/urn:li:activity:7253121919447658496------------------------------------"The two largest business opportunities on the planet today are AI and longevity." - Peter H. Diamandis"The merging of nature and humanity through the lens of synthetic biology will be the biggest transformative leap of the next couple hundred years." - Ben Lamm"Nature does things better and more efficiently than the machines we've made in the past." - Ron VoglewedeOver the past months, my team at Deloitte Consulting interviewed the best and brightest in BioTech and researched the state of the art in biology, chemistry, and information tech.xTech Futures: BioTech, exploring the burgeoning biotech economy is here!It would be easy to think of advancements in biotech as only relevant to PhDs and life sciences entities.But the truth is that if your company employs people, delivers products, or is geographically located on planet Earth, biotech is relevant for you and your business.Today we publish this report, tomorrow, we begin conversations with clients about the unparalleled, nature-inspired potential BioTech brings for business.I couldn't be more grateful for the team we had behind this effort. It takes an army.#BioTech#xTech#DeloitteConsultingRaquel Buscaino Abhijith Ravinutala Mike Bechtel Bill Briggs
Taylor Brockman Hillary Umphrey Daniel Greene Heidi Morrow Nathan Bergin Nkechi Nwokorie Connor Hage Adrian Espinoza Ben Hebbe Brianna Henley Deanna Gorecki Madelyn Scott Caroline Brown Kelly Raskovich
Hussain Mooraj Kulleni Gebreyes Asif Dhar Neal Batra Andrew Davis Neil Lesser Mathias Cousin Amit Agarwal Kasey Lobaugh John Peto David Schatsky Tracey Parry John Zeeman Shrey MaheshwariSource: https://www.linkedin.com/feed/update/urn:li:activity:7209633941568245760------------------------------------Everyone: "AI will take our jobs" 🫣AI accepting the job: 😂👇AI is just a tool.I think AI isn't about replacing humans, it's about upgrading humanity.Humans with real talents, real creativity, and real empathy are just as necessary as ever.What do you think?#AI#Creativity#GenAISource: https://www.linkedin.com/feed/update/urn:li:activity:7251944599848386560------------------------------------Yesterday I went to Google NYC to learn more about AI...Even though we've waved goodbye to the "Year of Gen AI" (2023), it looks like 2024 is gearing up to be just as groundbreaking.Here are some eye-opening insights:1. AI: The New Pace-Setter 🌟AI is not just keeping up; it's setting the pace, revving up the tech market's engine.Startups with an AI focus are seeing a whopping 20-40% higher investment from Seed to Series A compared to their non-AI peers (thanks, CB Insights for the data!).2. The Multimodal AI Revolution 🤹The future is now, with AI's creativity spanning text, speech, music, visuals, and video.Get ready for a world where AI is the new Renaissance artist.3. RAG: The Heart of AI Conversations 💬Enter Retrieval Augmented Generation (RAG). It's transforming chat-based search, with startups like Ironclad already replacing entry-level legal jobs.Companies like Freeplay and MongoDB are making AI integration a breeze.4. Foundations are Getting Stronger 🔮The big guns (OpenAI GPT-4, Google Bard, Meta LLAMA) are evolving rapidly, becoming more potent yet surprisingly more affordable.Think big: "Imagine the most powerful foundation model ever (capable of truly anything). Now, think of what you can build for that future.” In less than 5 years, that's not just a dream - it's our blueprint.☕ TLDR; In little over a year, AI has journeyed from exclusively "lab coats and PhDs" science to a sandbox for budding developers and entrepreneurs, and now, it's everyone's toy.But don't be fooled, this 'toy' is on track to become a tool – more indispensable than a hammer to a nail and more versatile than a Swiss army knife.My mind is buzzing with the possibilities.#ai#genai#llm#startups~ LucasFlybridge assembled a room full of investors, founders, AI builders, and Googlers. Thanks to our host Cherae Robinson and Google. Stellar event!Shoutout to Forest Coon who took feverish notes with me at the event.
--------------------
Last night I met Blake Hutchison, the CEO of Flippa.com.The man quietly brokering most of the small business deals on the internet. 🤝He taught me the cardinal rule of buying small businesses, and it's the exact opposite of what most entrepreneurs want to hear.↓↓↓99% of the businesses in the US generate less than $10m in revenue.Flippa is the M&A platform for this 99%.They've brokered over 450,000 deals to date.For the past year or so, I’ve been using Flippa as a source of business intel and inspiration.The site is a treasure trove of private company information!What is the domain name, customer niche, P/L, and margin that makes a business sell for 3-5x multiples?For aspiring entrepreneurs, this data is hard to find anywhere else.𝐋𝐚𝐬𝐭 𝐧𝐢𝐠𝐡𝐭 𝐈 𝐚𝐬𝐤𝐞𝐝 𝐁𝐥𝐚𝐤𝐞: 𝐰𝐡𝐚𝐭 𝐚𝐫𝐞 𝐬𝐨𝐦𝐞 𝐨𝐟 𝐭𝐡𝐞 𝐜𝐡𝐚𝐫𝐚𝐜𝐭𝐞𝐫𝐢𝐬𝐭𝐢𝐜𝐬 𝐭𝐡𝐚𝐭 𝐦𝐚𝐤𝐞 𝐚𝐧 𝐚𝐜𝐪𝐮𝐢𝐬𝐢𝐭𝐢𝐨𝐧 𝐬𝐮𝐜𝐜𝐞𝐬𝐬𝐟𝐮𝐥 - 𝐞𝐯𝐞𝐧 𝐟𝐨𝐫 𝐚 𝐟𝐢𝐫𝐬𝐭-𝐭𝐢𝐦𝐞 𝐚𝐜𝐪𝐮𝐢𝐫𝐞𝐫?Apparently the “Pets” niche is doing really well right now.But Blake cautioned, “you need to play to your strengths.”If you’re a tech consultant like me, maybe hold off on buying that “direct to consumer pet toy company” which advertises on TikTok. 😂Instead, buy a business near your niche which also needs help doing what you do best.For example, let’s say you acquire a business for $40k that’s consistently doing $15k in annual revenue.No business is perfect:A software tool may have hideous design and no SEO ranking but deep industry partnerships with 2-3 big, happy customers.Or, a business may look glamorous in design but have a high churn of new customers that don’t stick around.There’s always room to improve.Most first-time buyers on Flippa are about to make the same massive mistake I would have made!They're ready to storm in like Silicon Valley revolutionaries, determined to "disrupt" their newly acquired business.“Priority #1 after the acquisition is to protect the revenue.”Before you know why the revenue is working, your quick changes are more liable to break things than to fix them.- Get to know the repeat customers. Understand what they like and dislike.
- Get to know the business. What are its strengths and weaknesses?
- Be patient. Time is your friend.The math is beautiful in its simplicity. ($40k valuation, $15k/yr revenue).In ~2.5 years you can recoup investments and still hold the asset.This isn't just theory. Flippa is a live laboratory where these principles play out every day, in real-time, with real money.It's the kind of place where the small dreams of capitalism come to trade hands – and occasionally, with the right buyer and the right patience, those small dreams grow into something big.Love to see it! Thanks to Flippa.com, Ezoic, Stephanie Veal and Tory Gregory for hosting.#Entrepreneurship#DigitalEconomy#emergingtech#acquisitions#NYCSource: https://www.linkedin.com/feed/update/urn:li:activity:7262474878035939328--------------------Last Friday I took a quick business trip to Salt Lake City to give 3 presentations to leaders in accounting and finance.It was a brilliant group of professionals and colleagues in attendance.The topic: What is the future of business and emerging technology?One pinnacle question stood out among all 3 sessions:“How will Generative AI disrupt the way we learn and the way future workforces and generations are educated?”My $.02: In the short term GenAI is going to tempt us to be lazy - to find corner-cutting ways of doing the same work, but which yield less learning in return for more productivity.Some of us may feel dumber albeit faster to reach our goals.But, in the long term, GenAI will be a paradigm shift in our day to day learning, as a tutor better than any Wikipedia or TA could have been.I think for those with curiosity and ambition, GenAI is about to increase education engagement, personalization, and impact.All the while decreasing costs for the average consumer to access top-tier tutoring and upskilling.Recently our team had a great call with Sohan Choudhury founder of the Y Combinator backed startup, Flint.They’re doing for classroom tutoring what Wikipedia did for human knowledge: reducing barriers to accessing information and education.What about you? Would you leverage GenAI in your own professional education today?Would you let your kids use GenAI to help them on their homework?Special thanks to my Deloitte colleagues who made this SLC event a great success.Cassidy Carter Jessica Cloward Olivia Phillips Paige Pappas Daylan BirdAnd to my teammates Mike Bechtel Raquel Buscaino for the collaboration on this talk.#GenAI#Ai#Education#CPE#EmergingTech#Deloitte#SLCSource: https://www.linkedin.com/feed/update/urn:li:activity:7138201993319247872--------------------I recently learned my reputation needs constant work, and yours does too.I had a great chat with a colleague in the 30 Rockefeller building recently.He has the kind of mind that could revolutionize an industry.He’s brilliant and ambitious, but has one major problem.Nobody knows who he is, yet.For those of us newer in our career: marks of status or prestige are still missing.We’re nobodies.You’re probably thinking “I’ll let my great work speak for itself.” Noble, but naive.Truth is, the game is always on.And people need to know you before they’ll put you in.“Do not leave your reputation to chance or gossip; it is your life's artwork, and you must craft it, hone it, and display it with the care of an artist.” - Robert Greene, 48 Laws of PowerIronically, according to Greene, when crafting a reputation it doesn’t even need to be… good."Better to be infamous than anonymous," as the saying goes.Celebrities understand this intuitively.It's why Logan Paul can score face time with Trump, Kamala Harris will go on Call Her Daddy, and Joe Rogan experience will pick Elon Musk’s brain over a joint.Love 'em or hate 'em, you know 'em.And their disparate backgrounds don’t seem to stop them from doing impactful work.In summary:Laws of reputation and power are effecting your work and career whether you acknowledge them or not.It’s time to behave more strategically knowing that reputation exists, and it crucially matters.“Your reputation precedes you.” And there are ways to improve it.If you have no reputation at all, align your reputation with a person or symbol bigger than yourself.- Quote someone significant or get a job at a well respected company.- Be trustworthy and dependable.- Always show up, always add the most value, never drop the ball.Photos for example:i’m a proud beneficiary of the Deloitte generational brand. go green dot!And I think my personal brand is strengthened by living in#NYC. This doesn’t make me smarter, or even more successful, but it does make me a New Yorker.that’s a powerful message.And, finally, here’s a silly photo of a vision pro I demoed in office.if nothing else, i’d like to believe this photo helps credential me as a professional geek.In this game of business, you’re the artist.Your reputation? That’s the masterpiece.Importantly, just try to be yourself. Be authentic.I think people have a sixth sense to see through the bs.What else should people know about building personal brand, making impact, and standing out with their work?#impact#tech#reputationSource: https://www.linkedin.com/feed/update/urn:li:activity:7249758036724973568--------------------Andrew Yeung has done it again!Honored to spend the day hanging with great founders in#NYC.#OOO summit was a huge success.I have the infinitely gracious and generous LaToya Allen to thank for the invitation.Sam Parr wise and witty beyond belief. Grateful to have followed your journey since the earliest days of The Hustle, Hustlecon, and to see you in-person once again here in NYC. Hopefully i’ll be a member of Hampton soon enough. :)Steph Smith as a researcher and PPT presenter myself, you may be the best i’ve ever seen. Ruler of data storytelling. Elite.Shahed K. and Guillermo Rauch i’m a user of both of your products Loom and Vercel. Your grit and ability to generate the brightest ideas is reflected in the users. Most founders & builders today launch using your tech. I’m personally better for it. Thanks.#founders#startups#techSource: https://www.linkedin.com/feed/update/urn:li:activity:7230699789317816322--------------------I spent an afternoon with the brilliant minds at the Cornell Tech EMBA AI Club this weekend!Across the water from Manhattan on Roosevelt island, Cornell Johnson Graduate School of Management has a hard-working, ambitious cohort of Executive MBAs from all over the world.Rank #3 in AI according to CSRankings.On a monthly basis they entertain expert speakers for lunch. Fortunately, I slipped into the lineup too. 😄It's a true honor and a privilege.Our clients at Deloitte are finding increasingly creative and purpose-driven ways to deploy#AI today.They're realizing greater productivity and excellence while doing less of the work they hate.#AgeofWith.One of the best questions I had ever heard came from Michael L. Piggott.He asked: "If AI is bringing all these new beginnings, what is one thing you think will end?"My answer:#Authenticity.In a world of increasingly persuasive and convincing deep-fakes and pseudo-human messaging, authenticity may be our scarcest resource.What do you think? How will the value of authenticity be effected by this new age of automation?A very big thank you to the AI Club founders who hosted this excellent event and the whole group in attendance.
Keegan Elliot Fonte, Michael L. Piggott, Neelam NaikHopefully this is the first of many opportunities to collaborate.Source: https://www.linkedin.com/feed/update/urn:li:activity:7231312517367500804--------------------En-route to the Applied AI New Horizons Summit with Deloitte Consulting!A convening of 250 of the brightest minds in AI as elected by leadership.This is the tip of the spear representing a much larger group of AI professionals and enthusiasts across the firm.“We believe the power of AI lies not in the technology itself, but in the collective wisdom, creativity, and collaboration of those who work with it.” - Paula Payton, PhD Sanmitra Bhattacharya, PhDApplied == AI Experts who know how to roll up their sleeves and build the future.Applied == those brave enough to realize deeply technical solutions for our Fortune 500 clients, or to advise against AI when it’s a hammer looking for a nail.Applied == solutions that we only dreamt possible a mere 5 years ago, coming true with a lot of research and late nights today.The future is happening here at Deloitte University this week.I’m deeply grateful to be included.Summit speakers include senior leaders from NVIDIA, Microsoft, and Amazon Web Services (AWS).As well as many of my leaders from Deloitte: Bill Briggs, Christine Ahn, Amit Chaudhary, Jim Rowan, Eli M. DowAnd a special thank you to the leaders behind the scenes making this all possible.grateful to work with you all and spend time in-situ soon.Jeremy Covert, Giorgina Donati, MPH, Abria Perry, Joshua Rodriguez, Kelly Raskovich, Rachael N.Comment below if you’ll be there. I would love to meet you soon.👇#AI#GenAI#ConferenceSource: https://www.linkedin.com/feed/update/urn:li:activity:7252326237950427137--------------------I'm honored to share that tomorrow afternoon we go live to discuss the future of BioTech opportunities in human health!Mike Bechtel, Kulleni Gebreyes, and Hussain Mooraj have much to share.In the broadest definition of this term, our recently published report establishes BioTech as an opportunity for a revolution in...People, Products, and PlanetThis "People" dimension on human health is experiencing unprecedented disruption through...- AI aided drug discovery
- AI powered continuous measurement
- Gene edited bespoke medicine
- InSilico & InVitro simulated clinical testingThe result? Our average life expectancy may soon increase by over 10 years and health equity may truly become, well, equal.Through a confluence of emerging technologies, this future is truly achievable.But not without our collective efforts to tackle myriad problems head-on.Join us to learn more tomorrow at 12ET!#deloitte#linkedinlive#biotechSource: https://www.linkedin.com/feed/update/urn:li:activity:7216444183224422400--------------------The Printed BioTech Report is here! 📖We all live in a strange digital reality where most of our work is done in bits, not atoms.what a shame.our creativity deserves tangibility.Every now and then research, insights, and ideas should get a physical treatment.I couldn’t be more excited that this treatment is coming to Deloitte Consulting’s xTech Futures BioTech report.all 44 pages are now available in a stunning, glossy coffee table book!A huge thank you to our graphic designers Heidi Morrow and Connor Hage who made it look so nice that we all want a print.A special thank you to our leadership Mike Bechtel Bill Briggs Raquel Buscaino Hussain Mooraj who licensed and reviewed this emerging effort.And a massive congratulations+thanks to Abhijith Ravinutala, Taylor Brockman , Hillary Umphrey, Nathan Bergin, Nkechi Nwokorie for co-authoring and researching every word.If you’d like to chat about this research on the intersection of#BioTech#InfoTech and#AI feel free to DM me.Cheers to a bright future for our people, products, and planet! 🌎 🧬Source: https://www.linkedin.com/feed/update/urn:li:activity:7249141092925718528--------------------I just picked up an ŌURA ring and i couldn’t be more excited!It’s a smart ring with a tiny battery and sensors to track health.I’m going to use this as an excuse to make poor life choices.How do my Sleep, Activity, Readiness, and HRV scores react to misbehavior?What happens when I…
1. Have a few too many to drink
2. Have coffee past 5pm
3. Eat sugar before bed
4. Watch TV until i fall asleepBasically, i’ll be doing everything my parents told me not to do since I was 5.Over the next week i’ll be setting a baseline.(All good experiments start with control).Then, we’re off to the self sabotaging races - like Morgan Spurlock in Super Size Me.Anything else i should test or have you tried the same experiment?#science#health#wearablesSource: https://www.linkedin.com/feed/update/urn:li:activity:7238907576233447426
--------------------
Hot take: Silicon Valley’s secret weapon isn’t the VCs or Stanford CS degrees.it’s the art of living like you’re 21 and perpetually broke.more people should live life like they’re still in college.The problem is, if you’re like me, since college you’ve been gradually unwinding flexibility and increasing routines.At this point, i can hardly even remember what an all nighter feels like, or how it feels to have a best friend along with you for the Soylent-fueled ride (photo attached).I think we should all behave more like a peach-fuzzed, partially hungover, dorm room developer.1. Cultivate 4am epiphanies:stay up late on a random tuesday drinking, playing board games, and debating random topics of life and philosophy.You never know what thread of a world-changing idea will come from the spark of a simple one.2. Master useless skills:work on random passion projects that you think are cool and most people would think are useless hobbies.“Great ideas are forged not found.” - Farza Majeed3. Network like a freshman with free pizza:Talk to strangers and collect friends like they're limited edition Pokémon cards.Organize social clubs and group activities with complete strangers. Make fast friends with everyone you can.4. Put on an ill-fitting suit:Apply to 100 jobs like they’re your first.Reach out to 20 recruiters who just might take your career to the next level.For those of you living in a state of perpetual disorder, congratulations! You’re already ahead of the curve.For the rest of us who have traded spontaneity for stability, it’s time to smash a Red Bull and rediscover our inner college freshman.All of this social momentum will correlate more with success than any isolated all-work-no-play routine ever could.Success isn't just about grinding harder—it's about staying creative enough to see what everyone else misses.It might not make you rich, but it'll remind you what it feels like to be alive.When is the last time you did one of the things above?Shoutout to a college best friend and one of the smartest#SoftwareEngineers I know Nisarg Shah and the OG community builder Ryan Luu.#creativity#spontaneity#programmingSource: https://www.linkedin.com/feed/update/urn:li:activity:7237097791615848449--------------------Leaving the noise of#Manhattan behind to spend some hours on the water this weekend.I feel blessed to get out here with city views, blue skies, and good company.Wishing you a restful and peaceful labor day to do whatever puts the wind back in your sails.⛵️💨#restday#labordaySource: https://www.linkedin.com/feed/update/urn:li:activity:7236431615567048707--------------------I couldn’t feel more lucky to spend the day with the Deloitte Government & Public Services futures team in#DC!Mark Osis and I delivered a winning presentation inspired by the best: Mike Bechtel.With many experts in the room, we discussed the far-reaching potential of#AI to create#cognitiveautomation and help all of us find better health and creativity.We (at Deloitte) are not new to AI, nor its potential. But, there is also a renewed sense of urgency.This recent paradigm-shift in automation and information is just getting started.To the age old question asked from the backseat: “are we there yet?”The answer is still: “No.” 😊Thank you to our gracious hosts and the leaders who organized and influenced the conversation.Claudina Castro Tanco, Aurelio "PJ" Rivera, Tasha Austin-Williams, Ph.D., Shimon HorwitzSource: https://www.linkedin.com/feed/update/urn:li:activity:7232796586509045760--------------------My teammate at Deloitte came up with a clever idea for predicting the future.It's known as "second-order thinking".The concept is to look at the 2nd, 3rd, and 4th order consequences of a major technology or market event.Michael Lewis, the famous author of Liars Poker and The Big Short (among others) covers this in his book.To make fast investment decisions, the best traders at the Salomon Brothers performed this in seconds."Don't bet on the news, bet on the impacts."This can help tremendously in predicting the future or making investments.Take a revolutionary technology like#Autonomous cars for example.𝟭) 𝗙𝗶𝗿𝘀𝘁 𝗼𝗿𝗱𝗲𝗿: 𝗟𝗼𝗻𝗴 𝗰𝗼𝗺𝗺𝘂𝘁𝗲𝘀 𝗯𝗲𝗰𝗼𝗺𝗲 𝗲𝗮𝘀𝗶𝗲𝗿.Uber may become driverless and their margins may get much larger as a result.𝟮) 𝟮𝗻𝗱 𝗼𝗿𝗱𝗲𝗿: 𝗜𝗻𝗰𝗿𝗲𝗮𝘀𝗲𝗱 𝗥𝗲𝗮𝗹 𝗲𝘀𝘁𝗮𝘁𝗲 𝗽𝗿𝗶𝗰𝗶𝗻𝗴 𝗶𝗻 𝗱𝗶𝘀𝘁𝗮𝗻𝘁 𝘀𝘂𝗯𝘂𝗿𝗯𝘀.After all, if you can take Zoom meetings on your way into office, you might as well buy a bigger house on a few acres outside town.Perhaps LA is now the city of the future?Real estate pricing may decrease in cities and spread out.Parking lots and garages may be replaced with more restaurants or public gardens.𝟯) 𝗖𝗮𝗿 𝗼𝘄𝗻𝗲𝗿𝘀𝗵𝗶𝗽 𝗺𝗮𝘆 𝗯𝗲𝗰𝗼𝗺𝗲 𝗮 𝘁𝗵𝗶𝗻𝗴 𝗼𝗳 𝘁𝗵𝗲 𝗽𝗮𝘀𝘁.It's cheaper to rent a city-car than have your own parked idle in-garage.Perhaps, the only car you own is that old-school Porsche 911 you've always wanted for play?We've already seen this in parts of#NYC with good subway transit and much of#Europe which is connected by rail.What other places can you apply second order thinking?What other futures should we explore?Thanks to my teammates for the great ideas.Raquel Buscaino Mark Osis Daniel Greene Mike Bechtel Hillary Umphrey Taylor BrockmanCredit to Howie Mann for the great image too.#futures#startups#emergingtechSource: https://www.linkedin.com/feed/update/urn:li:activity:7229879856472182784--------------------Day 1 of the Applied AI New Horizons Summit is well underway! 🤖AI and ML are nothing new to the world or Deloitte, but recent progress is nothing short of astounding.How do you balance an enthusiasm and energy for the technology trends of the future while still keeping the main thing and staying helpful to organizations today?In this room full of data scientists, computer programmers, and machine learning experts modern AI: like#LLMs and#GenAI are just a new shade of the same core technology.#Transformers are just one new tool to add to our chest of an ensemble of deeply valuable models for clients.The goal?Let’s take data, make sure it’s good, it’s clean, it’s ready to work with.“Garbage In = Garbage Squared.” - Jim RowanLet’s fix first things first.And then?Let’s apply AI to core business problems and deeply valuable challenges.No compromises.This room is just a small collection of technologists, but to realize the full potential of AI “we need more leaders who are willing to help us stand up and forge new tomorrows.”Grateful for a few of our expert speakers this morning including Amit Chaudhary Christine Ahn Jim Rowan Bill Briggs Kenny Brown Tammy Montgomery Rachael N. and a few stellar partners I can’t mention here.Much to learn and much room for this team to grow!#AI#DeloitteUniversity#EngineeringSource: https://www.linkedin.com/feed/update/urn:li:activity:7252722992760127488--------------------Had a great time yesterday at Deloitte NYC’s GenAI popup experience!The event featured a new art installation of#genai art which were actually QR codes linking to AI client success stories.Thank you to our#NYC Market Leader Roger G Arrieux Jr, NACD.DC for hosting and to the office of GenAI for setting this up.Special shoutout to my friends in the GenAI Studio Jacob Pressman, Li Ke, and Jack Roche who fielded all my technical questions at the event.It’s impressive to see how nimble Deloitte engineering teams are in mastering this new technology and helping our clients build their most futuristic ideas.#genai#emergingtech#nyc#30rock#softwareSource: https://www.linkedin.com/feed/update/urn:li:activity:7141074027837652993--------------------Happy Election Day! 🇺🇸Here’s a little experiment on the intersection of elections, research tools, and AI.How’s that for a business school venn diagram? 😂I’ve felt for a long time that finding signal from noise during election season is far too difficult.Perhaps this is because the news cycle profits from our curiosity?So instead, I setup this little team of AI Agents to research and predict election results for me.Then i built a demo dashboard to compare forecasts from major media outlets.I’m using a new framework I learned recently at a NYC hackathon with my friend Ibrahim Khajanchi.CrewAI makes it fairly easy to setup an agentic flow just like this.It’s not perfect. Some of the retrieved data is old, and no longer accurate.But this is just the tip of the spear for Agentic AI.Do you see other ways this technology could be applied?Any ideas which can be useful more frequently than every 4 years?#AgenticAI#ElectionDay#emergingtechSource: https://www.linkedin.com/feed/update/urn:li:activity:7259565209709690881--------------------How Billionaire Charlie Munger Sets a New Years ResolutionCharlie Munger was one of the most successful investors of all time and business partner to Warren Buffett at Berkshire Hathaway.He had a famous, counter intuitive way to plan goals.Inversion.“Invert, always invert: Turn a situation or problem upside down. Look at it backwards. What happens if all our plans go wrong? Where don’t we want to go, and how do you get there?” - Charlie MungerSo what is inversion?"Instead of looking for success, make a list of how to fail instead–through sloth, envy, resentment, self-pity, entitlement, all the mental habits of self-defeat. Avoid these qualities and you will succeed. Tell me where I’m going to die so I don’t go there.”Taking a lesson from Munger, I decided to invert my own New Years resolution: to have the MOST creative year of my life.How to have the LEAST creative year of your life:1. Idolize yourself and ignore others needs
2. Do work that bores you
3. Only create perfect things
4. Fill every spare minute with distraction
5. Consume more than you create
6. Do all work alone, never involve friends
7. Keep your cards close, never share what you have made
8. Sleep in until your first appointment, never rise early to create
9. Doom scroll on social media frequently
10. Spend time with people who are uninspiring and uncreative
11. Drink often, be hungover
12. Over eat and, be slothful
13. Exercise irregularly, have low energy
14. Play many video games, strive to be addicted
15. Procrastinate on the things you find most interesting
16. Do not journal, do not ideate
17. Avoid learning new things
18. Only create if you are certain it will be a success
19. Create only things which are entirely original, never learn from others
20. Pursue instant gratification
21. Create small, unimpressive things
22. Never commit to an audacious dream
23. Wait for the “perfect” moment to begin
24. Practice indecision, never action
25. In all you do, believe to the core of your being, this too will failCheers to 2024 friends! May your creativity be blessed and your action compound into great opportunity and greater learning.#charliemunger#work#creativity #2024#newyearsresolutionSource: https://www.linkedin.com/feed/update/urn:li:activity:7149034290767429632--------------------GenAI images are taking over Google. 🤒This feels like the start of a long downward spiral into synthetic data and an internet full of lies.Is the same "cool tool" we once loved quickly becoming a cancer to truth?#GenAI#Search#KnowledgeSource: https://www.linkedin.com/feed/update/urn:li:activity:7250845170747731969--------------------Such an honor to be featured in the Oc Business Journal alongside brilliant hardworking peers of mine!I think it will be the first of many news features amongst this ambitious crew.Source: https://www.linkedin.com/feed/update/urn:li:activity:7132156018465116161--------------------Hilarious video of Waymo autonomous cars in SF! 😂🚗You won’t believe how ridiculous this is.A great reminder that intelligence comes in many different forms.Applications in language and conversation may be taking off, but we’re still a long way from#AGI (Artificial General Intelligence).If you define AGI as “AI that can do all things a human can,” we have so much room for progress.In this case, AI failing to do what 16 year old humans can, or 5 year olds in professional karting.Have you ever ridden in an autonomous car?#AI#selfdriving#autonomyThanks @curiosior for the video.Source: https://www.linkedin.com/feed/update/urn:li:activity:7229125603747123201--------------------What I learned by uploading 5 years of personal journals to AI.In the grand tradition of humans finding increasingly creative ways to avoid genuine self-reflection, I decided upon a new approach.Because why confront your demons yourself when you can have a silicon-based life form do it for you?The results may shock you.↓ ↓ ↓Every page of my journals is handwritten.Step one. Digitize every single page.
Step two. Teach the AI to be a therapist.
Step three. Upload everything to AI.Full post below. :)Please let me know what you think.And, what should I try next?#programming#therapy#GenAISource: https://www.linkedin.com/feed/update/urn:li:activity:7226223915012923394--------------------4 things I learned from a night with Flybridge Founders in#Brooklyn this week.1. AI is still beating markets and exceeding#VC expectations! 📈One quick example of this is the Flybridge AI Index started by Daniel Porras Reyes.It tracks top public AI companies and is characteristically outperforming S&P.No ETF yet, but i’ll be waiting Chip Hazard.2. AI applications are consumer, not just B2B. 👤I met one startup building AI-generated podcasts for “AnyTopic” your heart desires.And another, BoldVoice, which is helping Non-native English speakers overcome accents to be more fluent.They’re both crushing it.3. Where demand exceeds supply, innovation triumphs. 🪩We all know that NVIDIA’s top GPUs are in scarce supply.The ambitious PhD-level team at A2Labs is solving this problem with AMD instead.Their goal: to scale models to run at peak performance on smaller hardware, no#CUDA required.4. It’s NOT just AI. 💵 ✈️Consultants who are still reading this are in for a real treat.There is still room for problem solving in traditional spaces.Like travel points.One of the biggest talking points in the room was a new app to help you use credit card and hotel points more efficiently.point.me is making it easier than ever to travel like a PPMD, on points you earned while still an Analyst.——Thanks for throwing the best events Cherae Robinson! Looking forward to the next.What other cool#NYC startups am I missing here?Let me know what you think of those above!Source: https://www.linkedin.com/feed/update/urn:li:activity:7250505527053496320--------------------Just a few blocks from my apartment in New York City, a large digital clock looms over Union Square. ⏰It counts down the precious seconds until humanity's window to act on climate change closes.As I walk past the clock, I can't help but think about the role of technology in our fight against climate change.Specifically, the role of artificial intelligence. The power consumption of AI is staggering.For instance, training an average generative large language model (LLM) involves roughly 10,000 to 30,000 state-of-the-art Graphics Processing Units (GPUs) running at full speed.The cooling of these GPUs necessitates enormous amounts of fresh water - 185,000 gallons for a single model, equivalent to ten backyard pools.But is AI really the enemy? Or could it be a powerful tool in our fight against climate change?I just published a new Deloitte Field Notes from the Future article diving deeper into this topic.What do you think of AI's hunger for power?https://lnkd.in/euDt2b6QSpecial thanks to my teammates Ed Burns, Abhijith Ravinutala, Imelda Mendoza and Heidi Morrow for bringing this piece to fruition!#ai#energy#climatechange#genaiSource: https://www.linkedin.com/feed/update/urn:li:acti
A quick bioAs a Research Lead on Deloitte's Novel and Exponential Technologies (NExT) team, I work with Deloitte's Chief Futurist, Mike Bechtel, to help the world's largest enterprises harness tailwinds, dodge headwinds, and arrive at their preferred futures a little ahead of schedule. I leverage my background in software engineering, business strategy, and leadership to sense (and make sense of) what's new and next in emerging technology for our clients.I am a co-author of numerous emerging technology publications for the Office of the CTO, Bill Briggs and have been honored to keynote innovation frameworks on global stages from NYC to Switzerland and Puerto Rico. I am also a member of LinkedIn's distinguished, invite-only Top Voice program.I have a degree in Computer Science (specialized in Big Data) and started my career in full-stack software engineering at HP.On the weekends you might find me hacking together Al apps in coffee shops across Manhattan, or on a sailboat in the Hudson river.